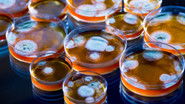
Image

1 Season
15 Episode
Oops I Changed the World
Tells the fascinating stories of accidental and surprise inventions that have transformed our lives.
- Year: 2022
- Country: United Kingdom
- Genre: Documentary
- Studio: CuriosityStream
- Keyword:
- Director:
- Cast:


 "
" "
" "
" "
" "
" "
" "
" "
" "
" "
" "
"








